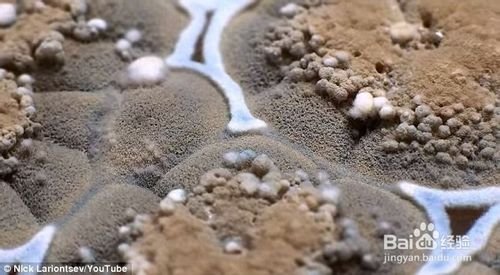
小学科幻小说如何写？

小学科幻小说如何写?
的有关信息介绍如下:开篇致胜
好的一本小说,尤其是悬疑类科幻小说,从开篇就应该有这样一些片段,这样读者才能更有趣味的阅读下去。
(赏析:罗伯特森·戴维斯,他在《谋杀和行走的灵魂》里是这样开头的:“当斯尼弗从枪套里抽出暗藏的凶器将我击倒在地,让我无法动弹时,我这辈子都没有这么惊讶过!”)

2
第一种,让人陷入无限遐想的场景描述。
开篇对一个奇异的环境简单的描述一下,让读者更能尽快的融入到你所描绘的世界中。
(赏析:“港口的天空飘满雪花,就像一台接收不到信号的电视机的屏幕。”威廉·吉布森的《神经漫游者》
“夜色中的哈利法克斯港是一道美丽的风景:在六月,麦克唐纳德大桥经常挤满了爱侣和游人。”斯比德·鲁宾逊的《记忆杀手》)

3
第二种,一开始就描述出一个能引起读者兴趣的角色。
读到一些对情景和人物的语句,读者马上就会被吊起胃口,想进一步了解这些人究竟发生了什么?到底发生了什么事情?那读者就会就此一路读下去。
(赏析:“斯隆太太的左手只有三根手指,但当她用这只手在厨房的台面上敲击时,第四和第五根残指上磨得发亮的小骨头桩子就像指甲一般敲得台面咔咔作响。”大卫·尼克尔的《斯隆家的男人们》“我是罗宾奈特·布劳海德,尽管这个名字女里女气,但我是个爷儿们。”弗雷德里克·波尔的《门》)

4
第三种,也是最难的一种,是在小说开头引用一则新闻摘要。
一些新闻摘要或者一则日记,再不然就用上一些与小说主题不相关的材料。尽量不要采取这样的方法,如果你下来没有写其他三种的技巧,那么极有可能被读者认为你在啰里八嗦的......
(赏析:斯蒂芬·金的恐怖小说《魔女嘉莉》和杰弗·里斯的恐怖小说《恶夜狂魔》就是用的这种方法开篇)

5
第四种,同时也是使用最广的一种方法,是从一件发生了一半的事情写起。
只要勾起悬念就是最成功的开篇,读者会问,后来究竟发生了什么?那个女的后来怎么样了?
顺序描写也很重要,千万不要像一个小学生一样,像流水账日记一般就这样写下去,倒叙插叙,就按照你的思维走吧!快动起来写一本你自己的科幻小说吧。
(赏析:“艾迪想见你。” “他想干什么?”尼塔问,“还想揍我一次?”(查尔斯·德·林特的小说《在一个女人的灵魂中》
人们总是热衷于倾听别人精彩的对话,只要你安排小说中的角色一直讲些有趣的事,你就可以轻松地诱导读者接着读下去。)

END
创作的秘密武器
1
创作的秘密武器
好吧,不是科学家?没有接触过“量子力学”,或者bababal~等等我也不知道都有什么,相信大家也都不是出身于科技科学领域吧!
(例子:看看弗雷德里克·波尔,他的小说里有人工智能、黑洞和量子论,可他甚至连高中都没毕业。)所以请不要在乎你的出身!
接下来会分级讲解,如何弥补你的知识与故事浅薄的,且看且珍惜。

2
第一件,也是最重要的一件武器,就是《科学新闻》、科学周刊,科学网,等等之类的新闻,(《自然》、《科学》、《细胞》、《美国科学院院报》、《物理评论快报》),看一看真实的事件。
(例子:文中介绍了恐龙克隆技术的可能性——即利用被俘陷在琥珀中的蚊子胃里的恐龙血液克隆出恐龙,或者暗物质,黑洞,平行时空)
然后就给你那些天马行空的想像,找一个归宿吧!一个专业的术语一个专业的名词,不用担心你写的与事实脱离,也不用去担心是否能看懂科学家的论文,反正我们写的是科幻小说啊!!哈哈~

3
第二件武器是做一个“科幻电影迷”
再也看不进去那些冗长无聊的论文、文字报道了?
那么就躺倒在沙发上,看完一部又一部科幻电影吧,给你的来源,给你的灵感,展开了去写,有想法就在本子上记录 ~总有你需要的。

4
秘密武器之三:很多科学家本身也是科幻迷。
去大胆的请教一些科学家吧,他们本身也就是科幻迷,(仅限于已经有著作的科幻作家或者脸皮就很厚的作家)。
那么其实能接触到他们的故事,本身就是一个写小说很棒的题材啊!
END
视角的选择
好吧!说了这么多,你应该已经开始想着手写小说了吧,但是有一个问题就会从你的脑子里蹦出来,我该用什么人称去写呢?

第一人称和第二人称的缺点
新手们在创作短篇故事或长篇小说的时候,常为视角的选择发愁。其实问题很好解决超过百分之九十的现代推理小说都采用同一种视角:限制性第三人称视角。
故事不是以第一人称(我怎样怎样),或那种让人厌烦的第二人称(你如何如何)
限制性指的是,虽然对所有角色采用第三人称代词(他,她,它)来叙述,但在每个相对独立的场景中,则会根据某一特定角色来变换叙述语气。
(例子:
“你好,斯佩德小姐,我是皮埃尔·塔迪弗。”他意识到自己那不大好听的魁北克口音此刻听起来是多么刺耳,提醒他自己是个外来分子。片刻之后,斯佩德小姐才想起,她认识此人。)

谈谈对话写法
文章中经常会出现一些对话吧!那么究竟怎么去写对话呢?
简单的说法就是用你现实生活中,多记载一些普通人的对话。做到让读者真实可感)




